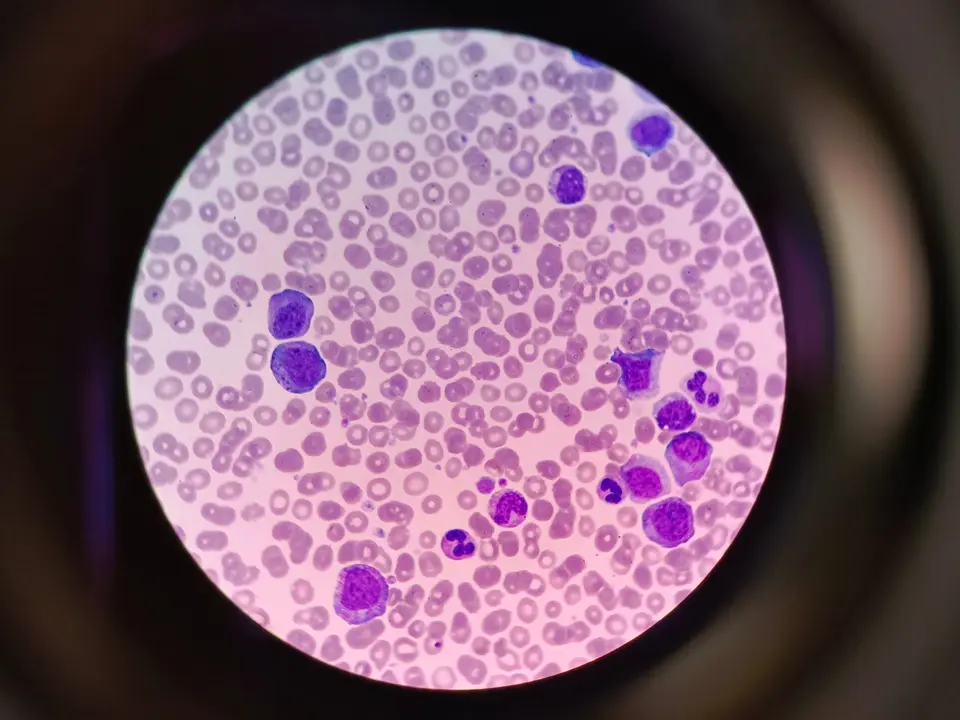

La biotecnología gallega tiene nuevo impulso institucional. El conselleiro de Educación, Ciencia, Universidades y Formación Profesional, Román Rodríguez, y el presidente del Clúster Tecnolóxico Empresarial das Ciencias da Vida (Bioga), José Manuel López Vilariño, firmaron este martes en la sede del grupo Zendal en O Porriño un convenio de colaboración con el que ambas instituciones intensifican su apuesta conjunta por el sector biotecnológico empresarial gallego.
El acuerdo, dotado con un presupuesto próximo a los 350.000 euros para el bienio 2026-2027 —de los que la Xunta aporta 250.000—, tiene como eje central conectar de forma más eficaz las capacidades de conocimiento generadas en el sistema científico gallego con las necesidades reales del tejido empresarial del sector, con el objetivo de multiplicar su impacto económico en la comunidad.
La elección del escenario no fue casual. Zendal, dedicado a la fabricación de vacunas y productos en el ámbito de la salud animal y humana, es uno de los referentes industriales del sector biotecnológico en Galicia y un ejemplo del tipo de empresa que este convenio aspira a multiplicar.
Atracción de talento, inversión y emprendimiento
El convenio articula una batería de actuaciones concretas orientadas tanto a reforzar el ecosistema existente como a proyectar Galicia como polo de atracción biotecnológica a escala internacional. Entre las iniciativas previstas figura un plan de atracción internacional dirigido a captar talento, spin-offs, startups, empresas e investigadores del ámbito biotech, así como acciones específicas para movilizar inversión privada hacia la transferencia tecnológica.
En el plano de la innovación colaborativa, el acuerdo incluye el programa ColaBIOrativa y el Biocamp, un hackathon centrado en el bioemprendimiento. La agenda de dinamización sectorial se completa con la organización de los Premios Bioga, el apoyo a la próxima Estrategia de excelencia de la biotecnología en Galicia 2026-2030 —cuya presentación está prevista en los próximos meses— y el programa Biotech Showcase Galicia, bajo cuyo paraguas se celebrará el evento Galicia Biodays los próximos 6 y 7 de mayo en Vigo.
Una década de trabajo conjunto con resultados
Este nuevo convenio se enmarca en una trayectoria de colaboración institucional que arranca en 2015. Desde entonces, la Xunta y Bioga han canalizado conjuntamente 1,5 millones de euros en sucesivos acuerdos que han contribuido al posicionamiento y la cohesión del ecosistema biotecnológico gallego, impulsando el talento, la innovación, la transferencia tecnológica y la competitividad del sector.
Román Rodríguez subrayó durante el acto el potencial transformador de la biotecnología sobre el resto de sectores productivos de Galicia, un argumento que se refleja también en su peso estratégico: el sector está identificado como iniciativa de alto impacto en el Plan gallego de I+D+i 2025-2027, y cuenta desde 2016 con una estrategia sectorial propia elaborada de forma conjunta entre la administración y el clúster.
El nuevo convenio busca contribuir al cumplimiento de los objetivos de la Estrategia de consolidación 2021-2025, al tiempo que sienta las bases de la siguiente etapa, la Estrategia de excelencia 2026-2030, que marcará la hoja de ruta del sector durante el próximo quinquenio. Galicia aspira, así, a consolidar su posición como uno de los ecosistemas biotecnológicos de referencia en España y a atraer la atención del mapa inversor europeo en ciencias de la vida.